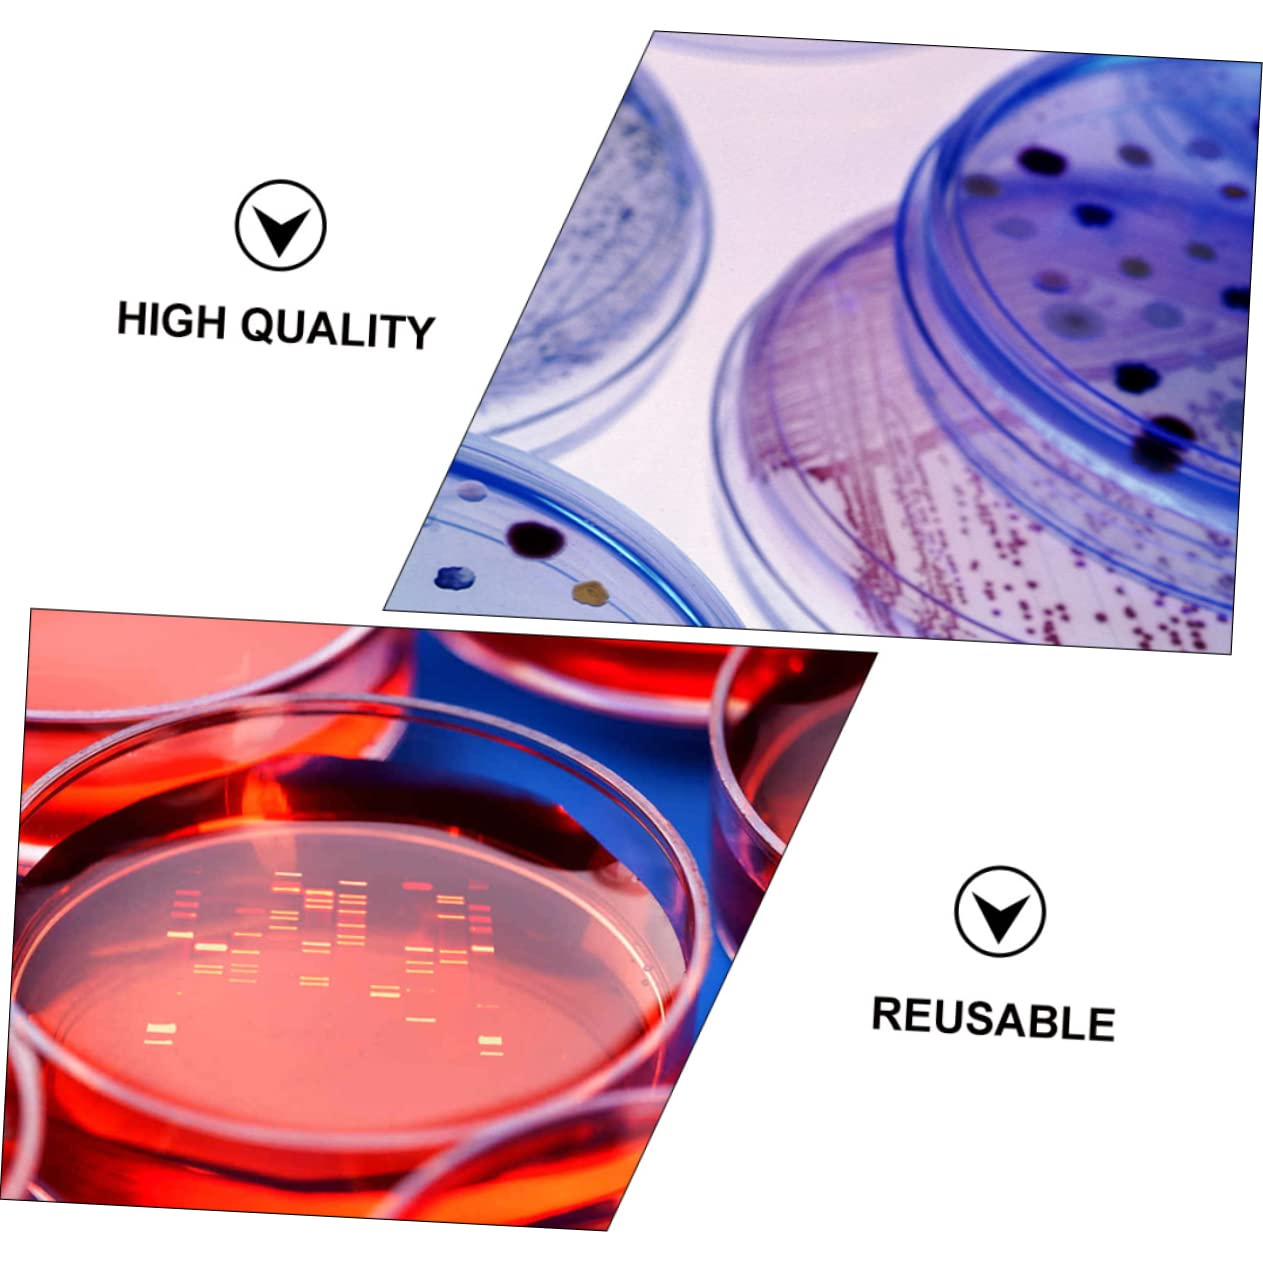
KICHOUSE 30pcs Set Petri Dish Seeding Petri DIY Petri Cell Dish Specimen Dish Laboratory Dish Lab Dish Petri Plate Science Project Supplies Plastic Transparent

Product Information
Specification
Brand : KICHOUSE
BulletPoint1 : Tissue petri dish-- every petri dish made of plastic material, which is a useful tool for you in science experiment,science petri dishes
BulletPoint2 : Seeding petri dish-- this product set are for experiment, biology, microbiology studies,laboratory petri dish
BulletPoint3 : Lab dish-- this petri in 90mm sizes, disposable design, enough quantity for your to use,science project supplies
BulletPoint4 : Petri dish with lids-- not easily broken, the lid of the designed to be easy to cover and reduce pollution,cell dish
BulletPoint5 : Experiment petri dish-- each petri made of plastic material and is a useful tool for your scientific experiments,petri dish for
Color : Transparent
ItemDisplayDimensions_Length : 3.54 centimeters
ItemDisplayWeight : 0.81 pounds
ItemName : KICHOUSE 30pcs Set Petri Dish Seeding Petri DIY Petri Cell Dish Specimen Dish Laboratory Dish Lab Dish Petri Plate Science Project Supplies Plastic Transparent
ItemPackageDimensions_Height : 3.94 inches
ItemPackageDimensions_Length : 10.63 inches
ItemPackageDimensions_Width : 5.91 inches
ItemPackageQuantity : 3
ItemTypeKeyword : science-lab-petri-dishes
ItemVolume : 1 cubic_centimeters
Manufacturer : KICHOUSE
Material : Plastic
ModelNumber : 9E4657ZIOFAG2503063
NumberOfItems : 1
NumberOfLithiumMetalCells : 1
PartNumber : 9E4657ZIOFAG2503063
ProductDescription : Package Include
30 x petri dishes (90mm)
Characteristics
- Color: Transparent decor.
- Size: 900X900X150cm/354X354X059inch science.
- Material: Plastic lab petri dishes.
- This product set are for experiment, biology, microbiology studies lids.
- Of course, you can dispose them after experiments where cultures might contaminate each other equipment.
- This petri in 90mm sizes, disposable design, enough quantity for your to use laboratory.
- Every petri dish made of plastic material, which is a useful tool for you in science experiment .
- All items in this set are made of plastic, which are , reusable and eco- . agar plates
Goods Information
petri dish rack Scientific experiment supplies specifically for children to monitor the growth of plants under different content and environmental conditions, so that your child feels like a professional scientist has his own petri dish! All items in this set are made of plastic, , reusable and
ProductSiteLaunchDate : 2024-10-01T23:24:54.212Z
Size : 9X9CM
SupplierDeclaredDgHzRegulation : not_applicable
UnitCount : 1
UnspscCode : 41000000